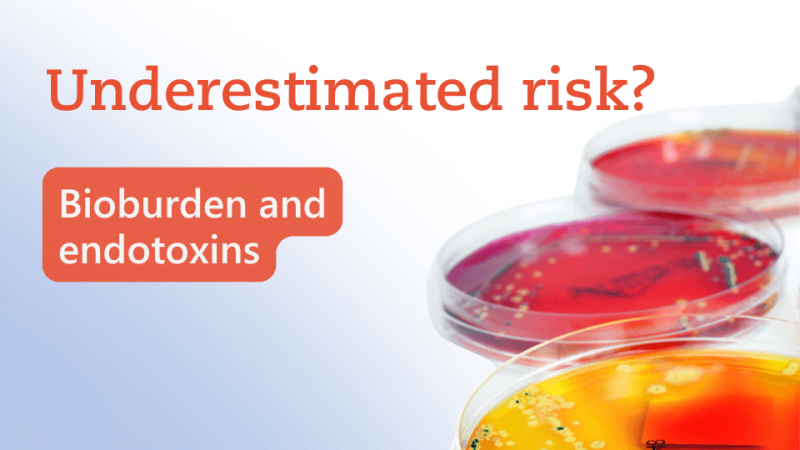

Tracking requirements: This is what lies behind test traceability
14/03/2023
Do you have any questions about the article or would you like to find out more about our services? We look forward to hearing from you!Make a non-binding enquiry now
Traceability of requirements (test traceability) is an important part of medical device quality management. The goal is to track and identify the stakeholders’ requirements for the product and ultimately ensure that those are met. What is the regulatory framework for test traceability? How can it be successfully implemented in practice? What is a traceability matrix? We have summarized the relevant regulatory background and derived practical recommendations for you.Traceability describes the procedure of tracing the relationships between artifacts of the development process. A definition of traceability" is given by ISO/IEC/IEEE 24765:2017 for the area of systems and software engineering. According to the standard, traceability is defined as a distinguishable linkage between two or more logical entities such as requirements, system elements, checks and tasks.Test traceability is particularly relevant for medical device manufacturers. In practice, its implementation can raise several questions, which we would like to answer in this article.
In order to meet the various legal and normative requirements, the implementation of test traceability is indispensable.
It is important to regularly review and update test traceability. This ensures that patient safety remains guaranteed and regulatory requirements are met.
Some RTMs contain further information such as priorities, references, and the status of the requirements, as well as traceability information about the origins and changes of the requirements.
In software engineering, three different traceability matrices are distinguished:
 Another possibility are matrices that show "only" the requirements and test ID (Table 2). This makes it easy to check whether each requirement has been verified with a test. However, it does not contain any information about where the requirement comes from.Table 2 Traceability-Matrix with requirement and test case
Another possibility are matrices that show "only" the requirements and test ID (Table 2). This makes it easy to check whether each requirement has been verified with a test. However, it does not contain any information about where the requirement comes from.Table 2 Traceability-Matrix with requirement and test case
 For RTM with larger data sets, Word or Excel documents can become very time-consuming and confusing. For these cases, various software solutions are available.
For RTM with larger data sets, Word or Excel documents can become very time-consuming and confusing. For these cases, various software solutions are available.
Best Regards
Why do manufacturers need to implement test traceability?
Test traceability is described and explicitly required in various guidelines and standards.- As an important component of ISO 13485, test traceability is dealt with in the following sections:
- Chapter 7.3.2 "Development planning" requires, under item "e"), that the organization documents procedures to ensure traceability of development results with respect to development inputs.
- According to Chapter 7.3.4 for "Development results" it is necessary that the development results are verifiable against the development inputs and must be approved before release.
- The International Electrotechnical Commission (IEC) standard DIN EN 60601-1 for medical electrical equipment also provides for traceability between tests and requirements. This standard specifies requirements for the safety of medical electrical devices and systems, including traceability between test results and the requirements on which the design and construction of the device was based.
- Finally, the MDR (Regulation (EU) 2017/745) indirectly insists on traceability in paragraph 10 of Chapter II of its "Essential Safety and Performance Requirements": "the confirmation that the device meets any defined chemical and/or physical specifications."
In order to meet the various legal and normative requirements, the implementation of test traceability is indispensable.
What are the benefits of test traceability?
The advantages of test traceability are obvious:- One of the most important benefits is its contribution to ensuring the safety and effectiveness of medical devices. Thanks to the traceability of all requirements, manufacturers have the certainty that the product meets all requirements and does not pose any risks to patients.
- Another advantage is that manufacturers can react fast to problems or defects in the product. By documenting all requirements, you can quickly locate the problem and identify what test is associated with it. Moreover, you can improve the quality of the product and increase customer satisfaction.
- Test traceability also facilitates compliance with regulatory requirements. Because all requirements are traceable and verifiable, you can more easily prove that you meet all MDR requirements, ensuring compliance.
- Test traceability is also suitable for test planning - in addition to retrospective verification that all requirements have been verified.
What are the requirements for implementing test traceability?
These requirements are among the prerequisites for you to successfully perform a test traceability:- Documentation and recording of tests: Detailed records of the tests performed, and their results should be available and must be retained throughout the life of the product.
- Repeatability and reproducibility of tests: Clear requirements for repeatability and reproducibility of tests should be defined to ensure that the results are reliable.
- Compliance with regulatory requirements: Measures should be taken to ensure that tests and test traceability comply with applicable regulatory requirements.
- Traceability of changes: Traceability measures and documentation of product changes are required to ensure that all changes are documented and approved before they are introduced into production. This point overlaps with the area of change management, which is not the subject of this blog post.
It is important to regularly review and update test traceability. This ensures that patient safety remains guaranteed and regulatory requirements are met.
How can manufacturers create test traceability?
In the first step of product development, the requirements of the various stakeholders are defined and listed in the specifications. In addition, further requirements for the safety of the product develop from the parallel risk management. This ultimately results in a wide range of requirements for the areas of electronics, mechanics, software, production and many more.The next step is to verify the implementation of the requirements. With test traceability, you ensure that all requirements have been tested. The traceability matrix visualizes tabularly these relationships between the requirements and tests of the development process.The easiest way to do this is to create a "Requirement Traceability Matrix" (RTM) as an Excel or Word document. In the RTM, the following contents can be related to each other:- The requirements including their ID to be tracked: e.g., functional requirements, performance requirements, safety requirements.
- The elements of the system or product that meet these requirements: e.g., functional modules, components, test protocols.
- The relationships between the requirements and the system/product elements. e.g., "met by", "verified by".
- The test status: "passed", "failed" or "in progress".
Some RTMs contain further information such as priorities, references, and the status of the requirements, as well as traceability information about the origins and changes of the requirements.
In software engineering, three different traceability matrices are distinguished:
- Forward traceability
- Backward traceability
- F+B traceability
 Another possibility are matrices that show "only" the requirements and test ID (Table 2). This makes it easy to check whether each requirement has been verified with a test. However, it does not contain any information about where the requirement comes from.Table 2 Traceability-Matrix with requirement and test case
Another possibility are matrices that show "only" the requirements and test ID (Table 2). This makes it easy to check whether each requirement has been verified with a test. However, it does not contain any information about where the requirement comes from.Table 2 Traceability-Matrix with requirement and test case  For RTM with larger data sets, Word or Excel documents can become very time-consuming and confusing. For these cases, various software solutions are available.
For RTM with larger data sets, Word or Excel documents can become very time-consuming and confusing. For these cases, various software solutions are available.Conclusion
Test traceability is an important part of medical device design control and quality management. It allows to identify and trace the requirements for the product and thus ensure their fulfillment. In addition, it can be used well for test planning. Regular review and updating of test traceability is important. This gives you, as a manufacturer, confidence that you are meeting regulatory requirements and that your products’ patient safety remains assured.Do you have questions about the practical implementation of test traceability for your medical devices? Would you like support in creating a test traceability matrix? Or are you interested in another aspect of verification and validation such as change management? Please feel free to contact us. Together we will find the best solution for your needs.Best Regards
Our blog posts are researched and created with the utmost care, but are only snapshots of the regulations, which are constantly changing. We do not guarantee that older content is still current or meaningful. If you are not sure whether the article you have read on this page still corresponds to the current state of regulation, please contact us: we will quickly place your topic in the current context.